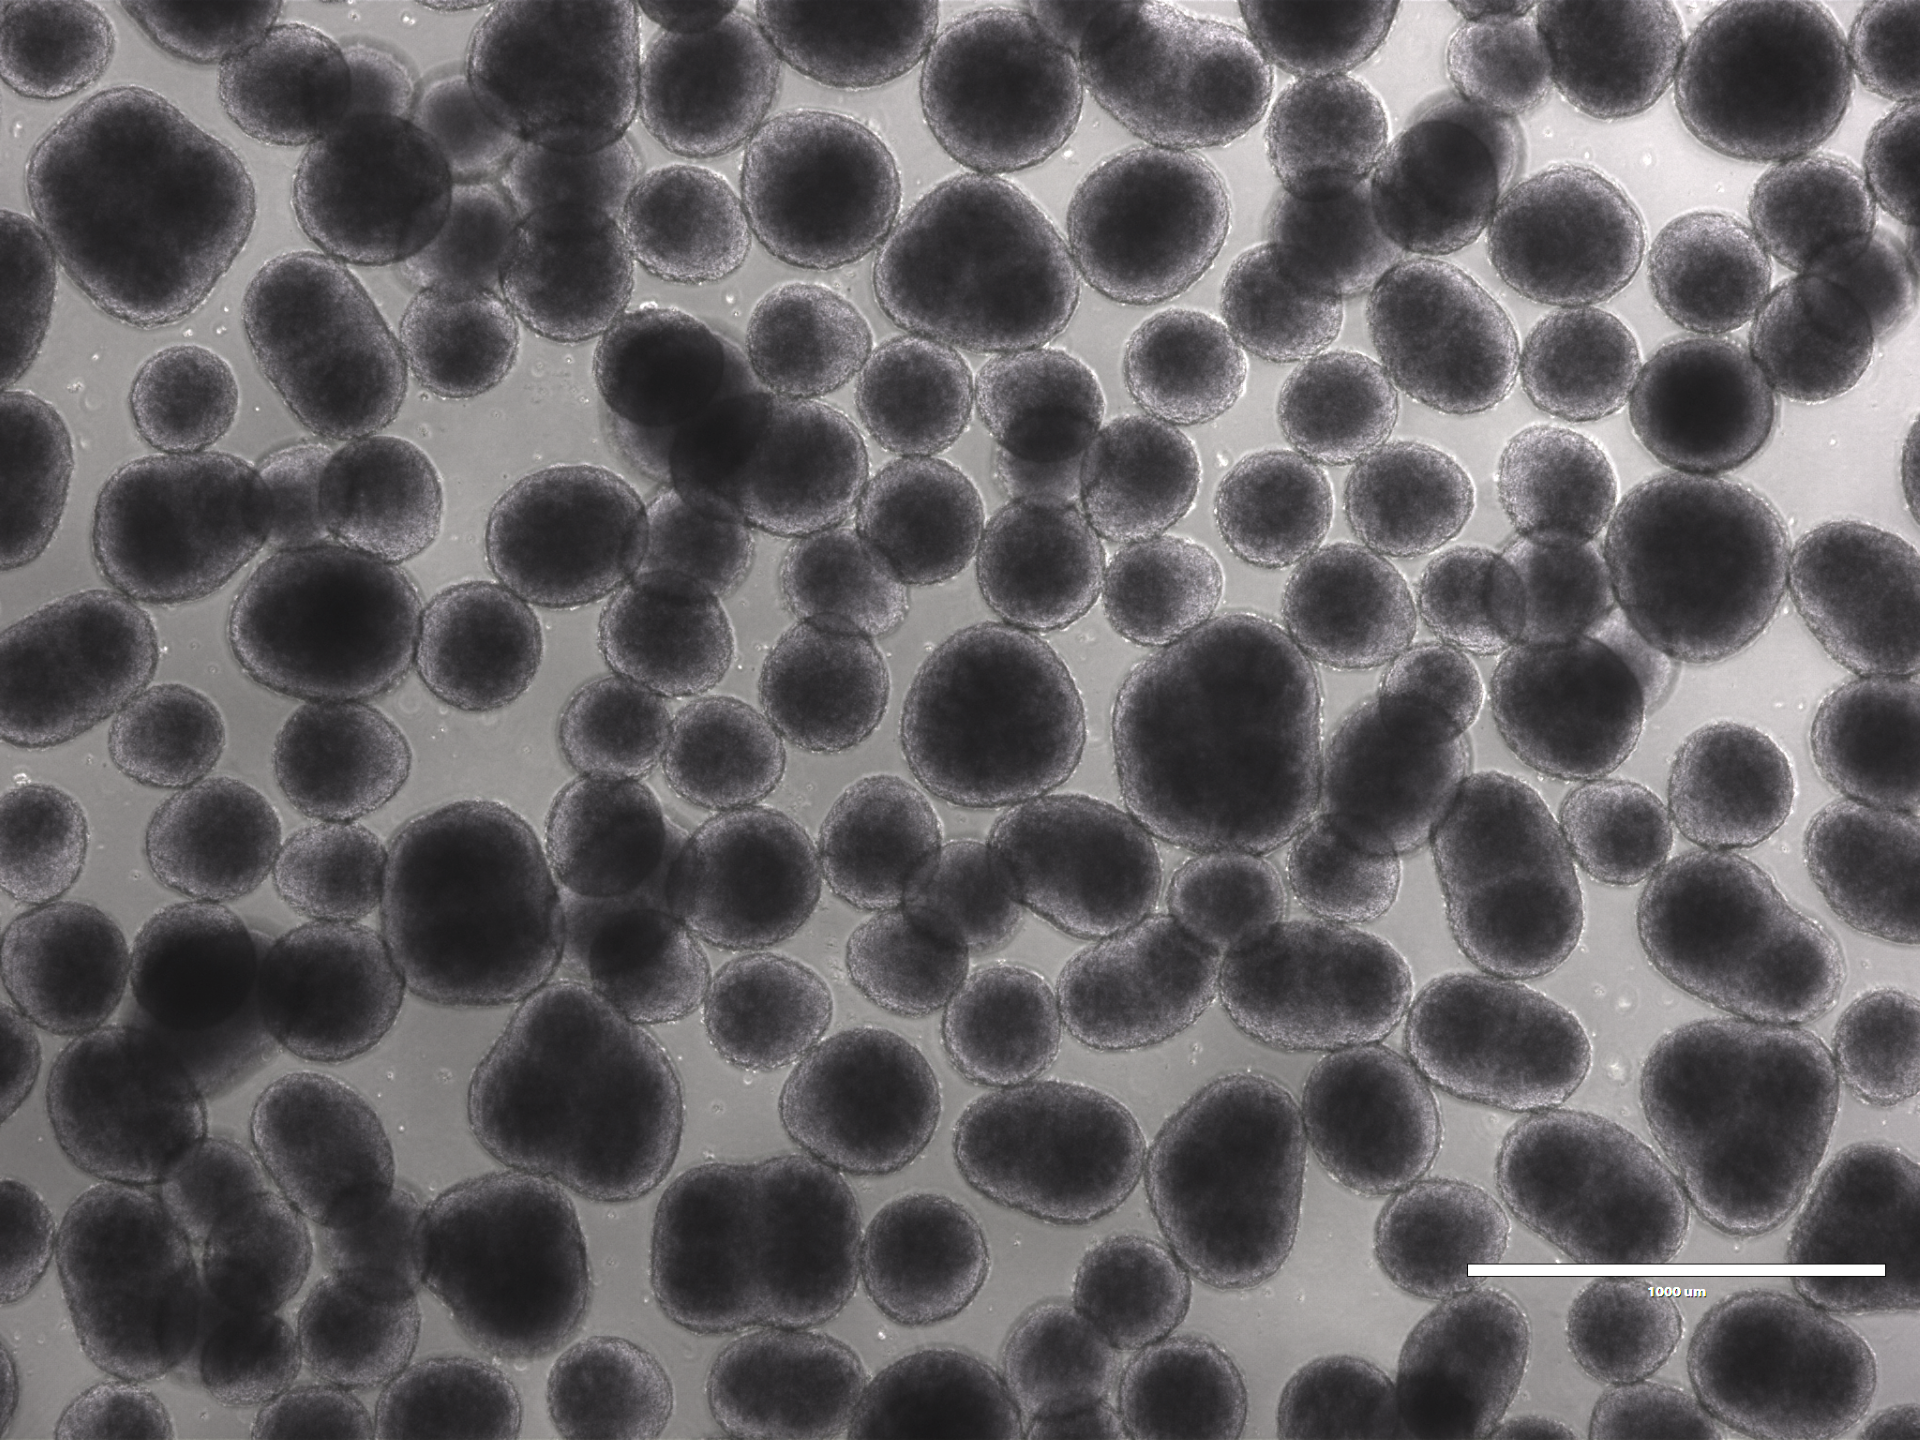
spheroid-image

Using HaloTag® Technology to Image Advanced Cell Models
Simon Moe, Promega Corporation
Introduction
HaloTag® Technology delivers a groundbreaking approach to protein labeling, providing researchers with a powerful tool to study protein dynamics with unparalleled precision and flexibility. This innovative technology employs the HaloTag® protein, which forms a covalent bond with synthetic ligands that can be easily swapped out for multiple applications1. This allows for the rapid and reversible labeling of proteins with various functional groups, such as fluorescent dyes, affinity handles, and other chemical probes. The high specificity and stability of the HaloTag system make it ideal for real-time, live-cell imaging, enabling detailed tracking of protein localization, interactions, and function within complex biological systems. By offering a robust and adaptable platform, HaloTag® Technology significantly enhances the research toolkit, driving forward our understanding of cellular processes and protein dynamics.
In addition to general applications in cellular analysis, HaloTag® ligands provide numerous advantages for imaging applications. These ligands enable the use of more stable and brighter dyes, facilitate multi-color labeling of the same target for applications such as pulse-chase experiments, and they support multiplexed imaging of multiple targets. The strong covalent binding between the HaloTag® protein and HaloTag® ligands ensures stable and persistent labeling, allowing for clear and reliable imaging over extended periods, even in dynamic or live-cell environments. This versatility extends to compatibility with super-resolution microscopy techniques, making HaloTag® ligands a powerful choice for visualizing cell structures at nanometer resolution.
Imaging Spheroids
Complex 3D cellular models, such as spheroids, provide several advantages over simple 2D cell cultures. The 3D architecture more closely mimics a physiologically relevant environment, providing cellular heterogeneity like actual tissues and displaying cell-cell and cell-matrix interactions not possible in 2D cultures. These 3D models provide optimal conditions to explore potential diagnostic therapeutics2. These biological advantages come with some imaging challenges. Due to their increased size, microscopy techniques for 3D cellular models often struggle with depth perception and visualization of cells located at the center of the structure. Real-time imaging measurements require long-standing signals that can last over many days, due to the increased timelines often modeled with 3D cellular models. Additionally, the viability of spheroids must remain unaffected by the imaging process over these extended periods.
The newest Janelia Fluor® HaloTag® Ligands were designed to be the brightest and most powerful ligands for cellular imaging. Below we highlight how Promega scientists have successfully used Janelia Fluor® HaloTag® ligands to monitor real-time neuritogenesis in cerebral spheroids. These applications highlight the versatility and utility of HaloTag® technology in complex experimental setups, enabling researchers to gain deeper insights into neuronal development and other cellular processes.
Monitoring Real-Time Neuritogenesis in Cerebral Spheroids
Promega scientists are interested in measuring the neuronal projections (neuritogenesis) of spheroids over long periods of time. To track neuronal projections over time, they employed the use of a HaloTag®-NanoLuc® fusion protein. The first step was to determine which promoter, CMV or SYN1, led to optimal expression of HaloTag® within a 3D structure. The advantage of using a HaloTag®-NanoLuc® fusion protein is that it enables a target protein to be monitored through both bioluminescence and fluorescence by merging NanoLuc® and HaloTag® technologies, respectively. Two different promoters were utilized (CMV and SYN1).
To accomplish this, the NanoLuc® Luciferase component of the HaloTag®-NanoLuc® fusion protein was measured. In this experiment, organoids were infected with AAV1-NLuc-HaloTag. The infected organoids were dissociated into a 2D culture and NLuc expression was measured from the dissociated organoids using the NanoGlo® Live Cell Substrate. An Extracellular NanoLuc® Inhibitor was applied to the dissociated organoids to reduce autoluminescence and decrease background signal, enabling the sensitive detection of intracellular NanoLuc® luminescence with a standard luminometer. In this experiment, the luminescent data collected is analogous to the amount of HaloTag® protein driven by a CMV or SYN1 promoter, providing a method for specific protein quantification (Figure 1).

One of the hallmark traits of the Janelia Fluor® HaloTag® dyes is their long-lasting signal. To demonstrate this capability, scientists explored the length of signal of one application of these dyes. Spheroids were infected with AAV1 driving dual reporters expression including HaloTag®-NanoLuc® as a fusion. Janelia Fluor® HaloTag® ligands were added at day 11 post AAV infection and cell nuclei were stained again with the NucBlue™ Live ReadyProbes™ Reagent before being imaged. Figure 3 shows fluorescence imaging of these spheroids at 20 days old (Fig 3.A) and 45 days old (Fig 3.B). AT 45 days, the HaloTag® ligand retained a strong fluorescent signal with a single ligand application, comparable to the fluorescent signal at 20 days. This underscores the effectiveness of HaloTag® ligands in tracking complex cell processes in real time over extended periods. Furthermore, the HaloTag®-NanoLuc® fusion protein is non-toxic to cells, providing a method to observe cellular phenomena over extended periods. Together, the combined use of the HaloTag®-NanoLuc® fusion protein with a Janelia Fluor® HaloTag® Ligand allows detailed visualization and quantification of protein expression in cerebral spheroid cultures.

Summary
References
- Los, G. V., Encell, L. P., McDougall, M. G., Hartzell, D. D., Karassina, N., Zimprich, C., Wood, M. G., Learish, R., Ohana, R. F., Urh, M., Simpson, D., Mendez, J., Zimmerman, K., Otto, P., Vidugiris, G., Zhu, J., Darzins, A., Klaubert, D. H., Bulleit, R. F., & Wood, K. V. (2008). HaloTag: A novel protein labeling technology for cell imaging and protein analysis. ACS Chemical Biology, 3(6), 373–382. https://doi.org/10.1021/cb800025k
- Zhao, Z., Chen, X., Dowbaj, A. M., Sljukic, A., Bratlie, K., Lin, L., Fong, E. L. S., Balachander, G. M., Chen, Z., Soragni, A., Huch, M., Zeng, Y. A., Wang, Q., & Yu, H. (2022). Organoids. Nature Reviews Methods Primers, 2(1). https://doi.org/10.1038/s43586-022-00174-y
Learn more about the HaloTag® Janelia Fluor Ligands.
Related Resources

Ligands for Super Resolution Microscopy
Learn the basics of super resolution microscopy, including how it works, its applications and two common techniques: STED and STORM..
Introduction to 3D Culture
Learn what 3D cell cultures are, why and how they are being used, and how to choose the optimal assay for your experiment.